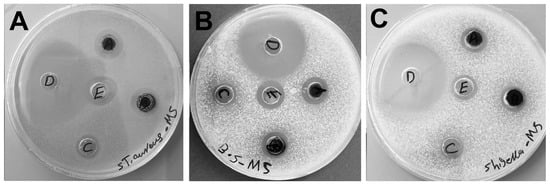

Abstract
Microalgae-mediated nanoparticle (NP) biosynthesis is a promising green synthesis method that overcomes the challenges of conventional synthesis methods. The novel Desmochloris edaphica strain CCAP 6006/5 was isolated, purified, and characterized morphologically and genetically. GC-MS analysis of the algal biomass (DBio) phytochemicals showed the abundance for elaidic acid (18.36%) and monoolein (17.37%). UV-VIS spectroscopy helped analyze the effects of the AgNO3 concentration, algal/silver nitrate ratio, temperature, reaction time, illumination, and pH on AgNP synthesis. DBio extract or cell-free medium (DSup) of D. edaphica successfully biosynthesized small silver NPs (AgNPs), namely, DBio@AgNPs and DSup@AgNPs, under optimum reaction conditions. TEM and SEM showed a quasi-spherical shape, with average diameters of 15.0 ± 1.0 nm and 12.0 ± 0.8 nm, respectively. EDx and mapping analyses revealed that silver was the main element, the NP hydrodynamic diameters were 77.9 and 62.7 nm, and the potential charges were −24.4 and −25.8 mV, respectively. FTIR spectroscopy revealed that the DBio@AgNPs, and DSup@AgNPs were coated with algal functional groups, probably derived from algal proteins, fatty acids, or polysaccharides, representing reductant and stabilizer molecules from the synthesis process. They showed significant anticancer activity against breast cancer cells (MCF-7), low toxicity against normal kidney cells (Vero), and potent inhibitory activity against Staphylococcus aureus, Bacillus subtilis, and Shigella flexneri. D. edaphica is a novel biomachine for synthesizing small, stable and potent therapeutic AgNPs.
1. Introduction
Owing to their superior biological and physicochemical properties, silver nanoparticles (AgNPs) have been used in a wide range of industrial, medicinal, and agricultural applications [1,2,3]. AgNPs are currently used in healthcare products and cosmetics. They are used in food packaging to increase the shelf life of foods [3,4]. Owing to their high reactivity, they have been used as potent anticancer agents against colon, liver, breast, and other cancers [5,6]. Additionally, they exhibit excellent biocidal activity against bacteria, fungi, and viruses [7,8,9]. Despite these significant applications of AgNPs, fabricating safe and biocompatible nanoparticles (NPs) for absolute usage remains a major issue. AgNP accumulation in the gastrointestinal tract may aggravate injuries such as abnormality of the epithelial cell microvilli and intestinal glands and an inflammatory response in intestinal native colonies. After gastrointestinal absorption of AgNPs, Ag ions accumulate in organs such as the liver, spleen, and kidney, which may cause undesirable health effects [3,10]. Recently, nanobiotechnology has enabled novel green synthesis approaches to produce AgNPs that are small, stable, and highly biocompatible compared with those synthesized using conventional methods [11,12]. In the green synthesis method, living cells and their purified molecules are the primary sources for reducing and stabilizing NPs [12]. These natural resources exist in the environment and can be readily obtained and cultured. For instance, plants, algae, fungi, bacteria, lichens, and actinomycetes and their purified molecules, such as proteins and polysaccharides, are potent biomaterials for NP synthesis [13,14]. This requires no toxic chemicals for the synthesis reaction; consequently, few to no hazardous compounds are transferred to the environment and other living organisms. Another advantage of green synthesis is the feasibility of coating the resulting NPs with many functional groups that occur in natural biomolecules, such as proteins, lipids, pigments, antioxidants, and fatty acids. These coronae impart the NPs with several advantages, such better stability in various salt-containing solutions and enhanced biocompatibility and selectivity than chemically or physically synthesized NPs [15,16]. Recently, microalgae have been considered one of the superior biofactories for NPs owing to their potential to detoxify and accumulate heavy metals from the environment, rapid growth, high yield, and ease of culture under normal environmental conditions [17]. The potential of microalgae to reduce precursors into their nanoforms continues to be investigated. Microalgae are enriched with many vital biomolecules, such as unsaturated fatty acids, antioxidants, vitamins, peptides, and phenolics [18]. Thus, NPs may be coated with these potent biomolecules, which may act as targeting ligands for cell receptors, therapeutic agents, or oxidative stress inhibitors [19]. Additionally, NPs have been produced in several shapes (cubic, spherical, triangular, and hexagonal) and sizes using microalgae. These biogenic NPs show high bioactivity against malignant and microbial cells and low toxicity against normal cells [12,20]. A significant factor in obtaining small and stable NPs using green synthesis methods is the optimization of the reaction parameters, such as the reactant concentration, pH, temperature, reaction time, and light [21]. In this study, we demonstrate for the first time the potential of the novel Desmochloris edaphica strain CCAP 6006/5 to synthesize AgNPs using two methods: one with a cell-free medium and another with cell biomass extract. We optimize the reaction conditions for synthesizing small AgNPs using the tested microalgae. To the best of our knowledge, this is the first study to demonstrate the presence of volatile biomolecules in the novel microalgae. The AgNPs are physicochemically characterized and applied against malignant and normal cells and Gram-positive and Gram-negative bacteria.
2. Results and Discussion
2.1. Algal Identification
The data analysis of the 18s rRNA sequence of the algal isolate showed that the sample was 97.8% identical to Desmochloris edaphica strain CCAP 6006/5 (Figure 1). The sequence was deposited in the NCBI website collection (accession number: OR826101). The morphological appearance of D. edaphica strain CCAP 6006/5 was examined using light microscopy (Figure 2). The micrographs illustrate that the sample presented a spherical shape, had an olive-green color, and formed clumps. They were surrounded by thin cell walls and contained chloroplasts with one large visible pyrenoid. Vegetative cells were either solitary or in packages. These data are consistent with those of Darienko et al., who identified Desmochloris edaphica CCAP 6006/5 genetically and morphologically using the SSU-ITS sequences and light microscopy, respectively. They found that the new species was spherical, with a diameter of 6.2–9.9 µm [22]. These single cells were surrounded by thin walls and had cup-shaped chloroplasts with 2–3 incisions covering almost the entire cell. A large pyrenoid surrounded by many starch grains was detected in the chloroplasts, whereas a large vacuole was detected in the young cells. Mature vegetative cells were spherical and existed either solitarily or in packages of 2–8 cells.

Figure 1.
The phylogenetic tree of Desmochloris edaphica strain CCAP 6006/5 was inferred from the 18S rRNA and constructed using the cluster method with MEGA4 software version 10.2.6.

Figure 2.
Light micrographs (A,B) reveal the morphological appearance of D. edaphica strain CCAP 6006/5. Scale bar 20 µm.
Gas chromatography–mass spectrometry (GC-MS) was used for the first time to detect volatile molecules in the aqueous extract of D. edaphica biomass (Figure 3 and Table 1). Elaidic acid (18.36%) was the most abundant fatty acid in the sample, followed by monoolein (17.37%), linoleic acid (12.83%), 2-monolinolein (9.24%), and palmitic acid (5.95%). Moreover, some aromatic monoterpenoids, such as acetic acid and [1-(4-isopropylphenyl)-2-methyl] propyl ester (6.6%), were also detected. This result highlights the importance of D. edaphica as an enriched source of unsaturated fatty acids for the food and pharmaceutical industries. Monoolein is considered an important fatty acid for drug delivery [23]. Additionally, these dominant fatty acids may be the primary stabilizing agents for AgNPs.

Figure 3.
GC-MS chromatogram illustrating the compositions of the volatile phytochemicals detected in the D. edaphica strain CCAP 6006/5 biomass extract.

Table 1.
Phytochemicals detected in the Desmochloris edaphica strain CCAP 6006/5 biomass extract using gas chromatography–mass spectrometry (GC-MS).
2.2. AgNPs Synthesis Using Desmochloris Edaphica Strain CCAP 6006/5
Characterization
The precursor concentration significantly influenced the synthesis of DBio@AgNPs and DSup@AgNPs. The data demonstrate that an increase in the AgNO3 concentration from 1 to 2 mM caused a blueshift in the NP wavelength from 451 to 422 nm for DBio@AgNPs and from 440 to 414 nm for DSup@AgNPs. Additionally, changing the AgNO3 concentration from 2 to 4 or 8 mM caused a redshift in the NP wavelength or did not form NPs. These results showed that the optimal AgNO3 concentration for synthesizing small DBio@AgNPs and DSup@AgNPs was 2 mM. Deviation from the optimal concentration of AgNO3 either promotes the development of NP clusters or prevents the formation of NPs. As the concentration of AgNO3 was increased while maintaining a constant volume of algal extract, the quantity of reductants was inadequate for facilitating the reduction of AgNO3 to AgNPs. According to Sobczak-Kupiec et al., an increase in the concentration of AgNO3 leads to the formation of larger-sized NPs and increases the aggregation of NPs [24].
Similarly, changing the algal extract/AgNO3 (VmL/VmL) ratio from 1:2A to 1:1, 1:4A, 1:9A, 1:2B, 1:4B, and 1:9B influenced the particle size. The optimum ratio for synthesizing small DBio@AgNPs was 1:9A at 414 nm, whereas the optimum ratio for synthesizing small DSup@AgNPs was 1:2A at 414 nm. Changing this ratio by increasing the volume of the algal extract or precursor resulted in the formation of larger or aggregated NPs. We conclude that the size of AgNPs is highly affected by the ratio between the reductants (algal biomolecules) and the precursor, as well as the precursor concentrations. Therefore, it can be inferred that the change in the AgNO3 concentration depends on the reducing agent concentration in order to achieve a balanced synthesis reaction [19]. Haji et al. showed that an increase in the AgNO3 concentration increased the average particle size [25].
The influence of temperature on the synthesis of DBio@AgNPs and DSup@AgNPs was investigated. The results showed that the optimum temperature for synthesizing DBio@AgNPs and DSup@AgNPs was 25 and 60 °C at 414 and 404 nm, respectively. Notably, an increase in the optimum reaction temperature resulted in a redshift of the NP wavelength, indicating the formation of unstable or large AgNPs. Moreover, the synthesis of DBio@AgNPs at 100 °C resulted in a pale-yellow solution, indicating an incomplete synthesis reaction at 404 nm [26]. The formation of DBio@AgNPs and DSup@AgNPs at a certain temperature might be attributed to the metabolic activity of the algal extract. The formation of larger-sized DBio@AgNPs at increased temperatures could be attributed to the response of algal biomolecules (reductants or stabilizers) to high temperatures, which could cause their inactivation, or denaturation. This could cause an unbalanced redox reaction, leading to the formation of unstable AgNPs or aggregates. Notably, DSup@AgNPs synthesis suggested that temperature is a significant factor in activating the DSup@AgNPs synthesis reaction. However, this could be attributed to the fact that the biomolecules responsible for the synthesis of DBio@AgNPs and DSup@AgNPs may not have the same chemical compositions and chemical behavior. A surge in the reaction temperature accelerated the formation of Ag clusters and decreased the AgNO3 concentration. Hence, uniform AgNPs were formed at a rapid reduction rate [27]. To sum up, at the optimum reaction temperature, the algal biomolecules become active, while increasing the temperature beyond that point could result in degradation, denaturation, or deactivation of biomolecules that are responsible for reducing and stabilizing NPs and the production of agglomerated AgNPs or an incomplete synthesis reaction [28]. Lengke et al. studied that the shape of AgNPs synthesized by Plectonema boryanum under-influenced the reaction temperature change. A spherical shape of AgNPs was dominant at 25–100 °C, whereas only octahedral shapes appeared at 100 °C [29]. Prasad et al. reported that the reaction temperature influenced the NPs’ size. The scholars found that the size of AgNPs synthesized by Cystophora moniliformis at a lower temperature than 65 °C was 75 nm, whereas NPs self-assembled and formed clusters at a temperature higher than 95 °C with a size of 2 µm [30]. Liu et al. found that the formation of NPs at higher temperatures may be because of an increase in the nucleation kinetics constant rather than a decrease in the growth kinetics constant [31].
To analyze the influence of the reaction time, DSup@AgNPs were synthesized at the optimal temperature (60 °C) for 15, 30, and 60 min. The data showed that increasing the reaction time from 15 to 30 or 60 min resulted in no change in the NP wavelength (407 nm). In general, an increase in the reaction time leads to an increment in the number of synthesized NPs, but only for a certain amount of time. Following this point, there might be an agglomeration of AgNPs due to their instability [32]. These data indicate that if the DSup@AgNPs were stable, there would be no effect of an increasing time on them. Exposure to illumination strongly influenced the synthesis of DBio@AgNPs and DSup@AgNPs. The synthesis of DBio@AgNPs and DSup@AgNPs under dark conditions did not form DBio@AgNPs and caused a redshift in the wavelength of DSup@AgNPs from 404 nm (under light exposure) to 430 nm (under no light exposure). These data suggest that biofabrication of AgNPs using algal extracts is a photoreduction process in which light energy plays an important role in activating the synthesis reaction for both DBio@AgNP and DSup@AgNP fabrication [19,33]. Patel et al. synthesized AgNPs using Scenedesmus sp. under dark and light conditions. The scholar found that AgNPs synthesized only under light conditions, suggesting the important role of light in the reduction reaction of AgNPs [34].
Changing the pH of the DBio@AgNP synthesis reaction from the initial pH (6.6) to 6 and 12 did not form AgNPs, whereas changing the initial pH to 7 and 8 resulted in a blueshift in the wavelength of DBio@AgNPs from 414 nm to 401 and 402 nm, respectively. The optimum pH for the synthesis of DSup@AgNPs was the initial pH 9.5, and changing this pH to acidic or basic conditions enhanced the aggregation of DSup@AgNPs. Gontijo et al. found that AgNPs were less aggregated at pH < 3 and > 7 because all the groups were protonated at pH < 3 and working against electrostatic interactions, whereas at pH > 7, all the groups were deprotonated, which favored repulsion between the NPs and discouraged their agglomeration [35]. To sum up, the optimum synthesis parameters for DBio@AgNPs and DSup@AgNPs are as follows: DBio@AgNPs: mixing 1 mL algal extract and 9 mL of 2 mM AgNO3 at 25 °C under illumination and pH 7 for 24 h; DSup@AgNPs: mixing 1 mL algal extract with 2 mL of 2 mM AgNO3 at 60 °C for 1 h under illumination and pH 9.5 for 24 h (Figure 4).

Figure 4.
Wavelengths of DBio@AgNPs (A–E) and DSup@AgNPs (F–K) synthesized using D. edaphica biomass extract and cell-free medium under various reaction conditions, including the reactant concentration (A,F), algal/AgNO3 ratio (VmL/VmL (B,G)), temperature (C,H), reaction time (I), illumination (D,J), and pH (E,K). (L) represent the wavelengths of DBio@AgNPs (golden NPs suspension) and DSup@AgNPs (reddish-brown NPs suspension) after adjusting all the optimum conditions.
To study the shape and size of DBio@AgNPs and DSup@AgNPs, the samples were examined using TEM (Figure 5). The data showed that DBio@AgNPs and DSup@AgNPs were uniformly distributed, with no agglomeration. DBio@AgNPs and DSup@AgNPs presented a quasi-spherical shape, but DBio@AgNPs had a few triangular NPs. The average diameters (nm) of DBio@AgNPs and DSup@AgNPs were 15.0 ± 1.0 nm and 12.0 ± 0.8 nm, respectively. Additionally, the TEM micrographs revealed the presence of algal organic matrix-coated NPs. These data have clarified for the first time the potential of D. edaphica CCAP 6006/5 to biofabricate silver nitrate into small AgNPs. However, our data were similar to the data reported by Pernas-Pleite et al., who synthesized AgNPs using a broth medium of unclassified microalgae isolated from the Tinto river estuarian waters [36]. They investigated the influence of the broth pH, media composition, and growth phase on AgNP synthesis. They found that these NPs had a quasi-spherical shape and a size range of 7–11 or 12–21 nm, respectively, depending on the absence and presence of chloride ions. Similarly, the AgNPs synthesized using Chlorococcum humicola presented a spherical shape and a nanosize range of 2–16 nm [37].

Figure 5.
Transmission electron microscopy (TEM) micrographs with frequency distribution histograms demonstrating the shapes and sizes of DBio@AgNPs (A,B) and DSup@AgNPs (C,D) synthesized using D. edaphica biomass extract and cell-free medium. Scale bar of (A,B) is 50 nm and of (C,D) is 20 nm.
Similar to the TEM micrographs, the SEM micrographs confirmed that the DBio@AgNPs and DSup@AgNPs had quasi-spherical shapes (Figure 6). To determine the elemental composition and distribution of the DBio@AgNPs and DSup@AgNPs, the samples were scanned using an EDx detector conjugated to the SEM. The main element detected in DBio@AgNPs and DSup@AgNPs was silver with a mass % of 83.81 ± 2.29% and 85.15 ± 0.11%, respectively (Table 2 and Figure 6). Trace amounts of other elements, including carbon, oxygen, chloride, zinc, copper, phosphorus, aluminum, and silica, were found. The presence of carbon, oxygen, chloride, zinc, copper, and phosphorus indicates the successful synthesis of AgNPs using D. edaphica. These elements are the major minerals present in algal nutrients and their bioprocess [38]. Aluminum and silica were found in small quantities of 0.2% and 0.6%, respectively, and could have been included because of the sample preparation method. These results are in agreement with those of Chokshi et al., who performed SEM-EDx analysis of AgNPs synthesized using Acutodesmus dimorphus. They found that 76% of the sample weight was silver, with the strongest peak at 3 keV. These data were confirmed through mapping analysis [39].

Figure 6.
Scanning electron microscopy (SEM) micrographs of DBio@AgNPs (A,B) and DSup@AgNPs (C,D) synthesized using D. edaphica biomass extract and cell-free medium. EDx (E,F) and mapping analysis (G,H) illustrating the elemental composition and distribution of DBio@AgNPs and DSup@AgNPs, respectively. Scale bar of (A,C,D) is 500 nm and of (B) is 200 nm. Scale bar of (G,H) are 10 µm and 1 µm, respectively.

Table 2.
Elemental composition of DBio@AgNPs and DSup@AgNPs synthesized using D. edaphica biomass extract and cell-free medium, respectively.
The hydrodynamic diameters (HDs) and potential charges of DBio@AgNPs and DSup@AgNPs were examined using a Zetasizer (Figure 7). The HDs of DBio@AgNPs and DSup@AgNPs were 77.9 and 62.7 nm, respectively, whereas their charges were −24.4 and −25.8 mV, respectively. The electronegativities of DBio@AgNPs and DSup@AgNPs could be related to the algal functional groups on their surfaces. Cekuolyte et al. synthesized AgNPs using various strains of Geobacillus spp. (encoded by residues 18, 25, 95, and 612). The authors reported that the HDs of all the AgNPs were <100 nm, with a zeta potential of −26.6 ± 0.5, −31.3 ± 0.8, −25.7 ± 0.8, and −27.4 ± 0.6 mV, respectively [40].

Figure 7.
Hydrodynamic diameter (nm) and zeta potential (mV) of DBio@AgNPs (A,B) and DSup@AgNPs (C,D) synthesized using D. edaphica biomass extract and cell free medium, respectively.
FTIR analysis was performed to study the surface chemistry of the novel DBio@AgNPs and DSup@AgNPs and the interaction of the algal biomolecules with the AgNP surfaces. The IR spectra of the Desmochloris edaphica biomass extract, supernatant, DBio@AgNPs, and DSup@AgNPs are presented in Figure 8 and Table 3. We found that O–H stretching existed in the D. edaphica biomass extract, supernatant, DBio@AgNPs, and DSup@AgNPs at 3346, 3437, 3366, and 3437 cm−1, respectively. Both DBio@AgNPs, and DSup@AgNPs have the same wavenumber, suggesting that the O–H group was very important for the AgNP synthesis process. Similarly, C–H stretching was detected in the D. edaphica biomass extract and supernatant at 2937 and 2849 cm−1, and shifted to be at 2926 and 2855 cm−1 in the DBio@AgNPs and DSup@AgNPs. These data suggested that an aliphatic chain coats the NPs’ surface and could play an important role in stabilizing the NPs. C=O stretching was detected in the supernatant, DBio@AgNPs and DSup@AgNPs at 1790, 1750 and 1740 cm−1, respectively, suggesting that aldehyde or esters could enhance the formation of NPs. N–H/C=C stretching was detected in the D. edaphica biomass extract, supernatant, DBio@AgNPs, and DSup@AgNPs at 1561, 2435/1632, 1632 and 1622 cm−1, respectively. This shift in the IRs’ wavelength and change in their intensities suggest successfully coating the NP surfaces with protein- or nitrogen-containing compounds. C–H bending was detected in the D. edaphica biomass extract, supernatant, DBio@AgNPs, and DSup@AgNPs at 1400, 1349, and (1461 and 1380) cm−1, respectively, suggesting the existence of organic molecules such as fatty acids. C–O stretching was detected in the D. edaphica biomass extract, supernatant, DBio@AgNPs, and DSup@AgNPs at 1116 and 1030, 1146 and 1045, 1060 and 1050 cm−1, respectively, suggesting that polysaccharides, alcohol or phenol or ester act as reactants during the synthesis process. C–H binding was detected in a range of 928–766 cm−1 in all the samples, indicating the existence of alkanes on the surfaces of NPs. C–Br stretching was detected in all the samples in the 528 to 659 cm−1 range. Interestingly, the number of IR peaks in the fingerprint area in the case of the D. edaphica biomass extract and supernatant was more than that in the case of DBio@AgNPs, and DSup@AgNPs, referring to the selectivity properties of the biological synthesis method in which specific hydrocarbons are responsible for the stabilization. To summarize, the functional groups present in the D. edaphica biomass extract and supernatant included O–H, C–H, C=C/N-H, C–O, C=O, and C–Br, suggesting the presence of organic molecules such as proteins, fatty acids, and polysaccharides. Although there were common functional groups between the D. edaphica biomass extract and supernatant, including O–H, C–H, C=C/N–H, C–O, and C–Br still, there were differences in the IR wavenumber, intensities, and the existence of new IRs such as C=O in the supernatant.

Figure 8.
Fourier transform infrared spectroscopy (FTIR) analysis of the algal biomass extract, cell-free medium, DBio@AgNPs, and DSup@AgNPs, illustrating the chemical composition of the NP surfaces.

Table 3.
Functional groups in the biomass extract and cell-free medium and surrounding the DBio@AgNPs and DSup@AgNPs synthesized using D. edaphica biomass extract and cell-free medium, respectively.
DBio@AgNPs and DSup@AgNPs had functional groups similar to those in the D. edaphica biomass extract and supernatant, such as O–H, C–H, C=C/N–H, C–O, C=O, and C–Br. The IRs of these functional groups were slightly shifted and had different intensities compared with the IRs of the D. edaphica biomass extract and supernatant. These data suggest that AgNPs were synthesized because of the bioreducing properties of the D. edaphica extracts. The existence of O–H, N–H, C–O, C–H, C=C and C=O indicates that the proteins and polysaccharides could be capping and stabilizing agents, whereas the fatty acids could be responsible for stabilizing the AgNPs. GC-MS showed that elaidic acid (18.36%) was the most abundant fatty acid in the sample, followed by monoolein (17.37%) and linoelaidic acid (12.83%), suggesting that these fatty acids could be the major stabilizers of AgNPs. We hypothesized that these fatty acids coated the surface of AgNPs. For instance, in the supernatant and DSup@AgNPs, IRs located at 1790 and 1740 cm−1, respectively, corresponding to C=O, matched that existence in the elaidic acid range. Also, IRs located at 1380 cm−1 were detected in DBio@AgNPs and DSup@AgNPs, corresponding to the C–H of elaidic acid. The IR peaks at 2855, and 2926 cm−1 correspond to the C–H of linoelaidic acid surrounding NPs. These data agree with Mudhaffar et al., who reported the IRs of pure linoelaidic acid at 2927 and 2855 cm−1 [41]. Lu et al. coated cobalt NPs with oleic and elaidic acids and found that the IR peaks of the pure acids were located at 1715 cm−1, corresponding to C=O, while it was shifted to be 1550 cm−1 in NPs after being coated with fatty acids. The authors detected a board peak at 683–611 cm−1, referring to the CH=CH of both acids [42]. However, further studies are required to explore the exact mechanism of AgNP synthesis using D. edaphica extracts. Mora-Godínez et al. synthesized AgNPs using cell pellets, cell-free medium, and cell pellets with a free medium of Desmodesmusabundans at low (LCA) and high (HCA) carbon acclimation [43]. The authors found that the surface of the AgNPs was composed of amides (N–H), polysaccharides (CH2 and CH3), and fatty acids (C=O and O–H), which were the main capping agents during the synthesis process.
2.3. Antiproliferative Activity of DBio@AgNPs and DSup@AgNPs
The antiproliferative activities of DBio@AgNPs and DSup@AgNPs against breast cancer cells (MCF-7) and normal kidney cells derived from African green monkey (Vero) were studied using the MTT assay (Figure 9). The results revealed that DBio@AgNPs and DSup@AgNPs significantly reduced the cell viability in a dose-dependent manner. At the highest concentration of DBio@AgNPs and DSup@AgNPs (500 µg/mL), the MCF-7 cells viability was reduced to 11.2% and 5.2%, respectively, whereas 34% and 47.6% of viable Vero cells was detected at 500 µg/mL of DBio@AgNPs and DSup@AgNPs, respectively. These results reveal that DSup@AgNPs are more potent antiproliferative agents than DBio@AgNPs. Among the two NPs, DSup@AgNPs showed more selectivity toward malignant cells than toward normal cells; consequently, they could be more biocompatible agents toward normal cells. This could be attributed to the influence of the AgNP size on the biological activities. Small AgNPs have a large surface area in contact with the plasma membrane, enabling more Ag ions to enter cells and cause cellular disruption [44]. Moreover, the chemical composition and concentration of the functional groups of the algal coronae surrounding the NPs surface can interfere with their cellular internalization mechanism and consequently impact their antiproliferative activity [19]. The colloidal stability of NPs and their tendency to form aggregates in the cellular environment are other factors that influence their toxicity [45]. More studies are required to understand the mechanism of toxicity of DBio@AgNPs and DSup@AgNPs against MCF-7 and Vero cells. Park et al. reported that small AgNPs (20 nm) showed significantly higher metabolic toxicity against both L929 fibroblasts and RAW 264.7 macrophages than larger AgNPs (80 and 113 nm) [46].

Figure 9.
Cell viability of MCF-7 (A) and Vero (B) cells before and after being treated with DBio@AgNPs and DSup@AgNPs synthesized using D. edaphica biomass extract and cell free medium, respectively. **** p < 0.0001, *** p < 0.0001, and ** p < 0.005.
2.4. Inhibitory Activity of DBio@AgNPs and DSup@AgNPs against Bacterial Cells
Pathogenic bacteria such as Staphylococcus aureus are among the common Gram-positive bacteria that cause widespread skin and respiratory clinical infectious diseases, whereas Shigella flexneri is a Gram-negative facultatively intracellular pathogen responsible for bacillary dysentery in humans [47,48]. Bacillus subtilis is a well-characterized, non-pathogenic model organism used in microbiological and biochemical studies [49]. Due the tendency of the bacteria to acquire antibiotic resistance, discovering new drugs is a necessity. The biocidal activities of 1 mg/mL of DBio@AgNPs and DSup@AgNPs were examined against S. aureus, B. subtilis, and S. flexneri for 24 h using the agar well diffusion and resazurin-based microdilution methods (Figure 10 and Table 4). DBio@AgNPs and DSup@AgNPs showed excellent biocidal activity against Gram-positive and Gram-negative bacteria; however, their activity was higher against S. aureus and B. subtilis than against S. flexneri. The biocidal activities of ciprofloxacin, DBio@AgNPs, DSup@AgNPs, AgNO3, and Chem@AgNPs against the tested bacteria are shown in Table 4. In the order of decreasing biocidal activity, they can be arranged as follows: ciprofloxacin > biogenic AgNPs > AgNO3 > Chem@AgNPs. Notably, the inhibitory activity of Chem@AgNPs was weak against S. aureus and B. subtilis and was zero against S. flexneri compared with that of biogenic AgNPs. Silver nitrate showed an inhibitory effect against the tested bacteria; however, it was less than that of biogenic AgNPs against S. aureus and B. subtilis and similar to that of biogenic AgNPs against S. flexneri. The more significant biocidal effect of DBio@AgNPs and DSup@AgNPs against the tested bacteria compared with that of Chem@AgNPs could be attributed to the chemical nature of the biomolecules surrounding the AgNPs, which could influence their biocidal activity by facilitating the cellular uptake of these NPs through their interaction with biomembranes. These data suggest that algal corona-surrounded AgNPs could enhance their biocidal potential. AgNPs were found to be more effective against Gram-negative bacteria than against Gram-positive bacteria. The cell wall of Gram-negative bacteria has a thick lipopolysaccharide (LPS) layer and a thin peptidoglycan (PG) layer, whereas Gram-positive bacteria have thin LPS and thick PG layers, which could affect the cellular uptake of AgNPs and, consequently, their biocidal activity [50,51]. Moreover, the positively charged AgNPs showed greater bacterial activity than the negatively charged AgNPs. This could be attributed to the theory that as positively charged ions, silver is readily attracted to negatively charged molecules such as sulfur, phosphorus, and proteins of cell membranes, which could increase the cellular uptake and biocidal activity [51,52]. Our data revealed a significant difference from prior investigations, indicating that S. aureus was the bacteria most susceptible to DBio@AgNPs and DSup@AgNPs, followed by B. subtilis and S. flexneri. This represents another significant advantage of our biogenic AgNPs in terms of the biocompatibility against mammalian cells, assuming that cationic NPs are more toxic than those with neutral or negative surface charges [53,54]. Additionally, we believe that the high toxicity of DBio@AgNPs and DSup@AgNPs against Gram-positive bacteria could be attributed to the negatively charged functional groups on the AgNP surfaces, which facilitate the entry of these NPs through unknown specific mechanisms. Additionally, this could be related to the nature of the bacterial strain (resistance potential, metabolic activity, and cellular mechanisms), which could interfere with AgNP uptake [55]. Further studies are required to investigate the influence of the algal corona on NP cellular uptake. Kong et al. studied the effect of AgNP size on multiple biological systems [56]. They have shown that smaller AgNPs exert greater toxicity than large ones against bacterial activities such as bioluminescence, enzymes, and enzyme biosynthesis.
Figure 10.
Inhibitory activity of ciprofloxacin (5 μg/mL), DBio@AgNPs, DSup@AgNPs, and Chem@AgNPs (1000 μg/mL) against Staphylococcus aureus (A), Bacillus subtilis (B), and Shigella flexneri (C). Handwritten letters on the petri dishes refer to A: DBio@AgNPs, B: DSup@AgNPs, C: Chem@AgNPs, D: ciprofloxacin, and E: AgNO3.

Table 4.
MIC (µg/mL) of DBio@AgNPs and DSup@AgNPs and inhibition zone (mm) of ciprofloxacin, DBio@AgNPs, DSup@AgNPs, Chem@AgNPs, and AgNO3 against Staphylococcus aureus, Bacillus subtilis, and Shigella flexneri.
3. Material and Methods
3.1. Algal Isolation, Culture, and Identification
The algae used in this study was isolated from soil samples collected in Riyadh, Saudi Arabia. The samples were transferred to the lab and kept in sterilized Petri dishes containing BG-11 media under illumination (2000 ± 200 lx) in an incubator for 1 week. Later, the samples were purified according to the method described by Bolch et al. [57], as presented in a previous study [58]. The purity of the samples was examined under a light microscope. The purified sample was then cultured in a 1000 mL flask under the same growth conditions but with additional agitation using an air pump. The samples were morphologically identified using a light microscope. To genetically identify the sample, the genomic DNA was extracted using a kit (Attogene, Austin, TX, USA) according to the manufacturer’s instructions. PCR was used to amplify the sample using the forward primer CCTGGTTGATCCTGCCAG and reverse primer TTGATCCTTCTGCAGGTTCA [59]. The amplicons were sent to Macrogen for 18s rRNA sequencing. The phylogenetic tree was constructed using the cluster method and MEGA4 software version 10.2.6. The number at each branch refers to the bootstrap values for the % of 1000 replicate trees calculated by the neighbor-joining statistical method.
3.2. Algal Extract Preparation and Phytochemical Content Analysis
On day 15 of the algal culture, the microalgae were centrifuged at 4700 rpm for 10 min to collect the cell-free medium, which was filtered using Whatman filter paper No. 1. The filtrate (solution 1, referred to as DSup) was used to synthesize AgNPs. The biomass was washed at least thrice with distilled H2O and freeze-dried using LYOTRAP (LTE Scientific, Greenfield, UK) for 24 h. The dried biomass was mixed with glass beads, vortexed, and crushed to a fine powder. The algal biomass extract was obtained by mixing 200 mg of the algal powder with 100 mL of distilled H2O and boiled in a water bath at 60 °C for 30 min. The mixture was cooled to room temperature and centrifuged at 4700 rpm for 10 min. The supernatant was filtered using Whatman filter paper No. 1 to obtain the final filtrate (solution 2: DBio), which was used to synthesize the AgNPs. Notably, the volatile biomolecules in the algal biomass extract were analyzed using Trace GC-TSQ mass spectrometer (Thermo Scientific, Austin, TX, USA) with a direct capillary column TG−5MS (30 m × 0.25 mm × 0.25 μm film thickness) according to the method described in our previous study [19].
3.3. Green Synthesis of AgNPs Using Algal Biomass and Cell-Free Medium Using D. edaphica and Physicochemical Characterizations
3.3.1. Optimization of AgNP Synthesis Using Microalgal Biomass and Supernatant
We extracellularly synthesized AgNPs using the algal D. edaphica strain CCAP 6006/5 biomass extract (DBio) and cell-free medium (DSup) by controlling the reaction parameters, such as silver nitrate concentration, the algal extract/silver nitrate (VmL/VmL) ratios, temperature, reaction time, illumination, and pH. To study the effect of various AgNO3 concentrations on the synthesis reaction involving DBio@AgNPs and DSup@AgNPs, 1 mL of algal extract was mixed with 2 mL of 1, 2, 4, and 8 mM of AgNO3. All the other reaction conditions (25 °C, light exposure, pH initial without adjustment for 24 h) were kept constant. After 24 h of incubation, the wavelengths of the NP suspension aliquots were measured at each concentration using UV-VIS spectroscopy (Model UV-1800, Shimadzu, Kyoto, Japan). The optimum concentrations were determined based on the lowest AgNP wavelength value in the range of 400–460 nm. The effect of the algal extract/silver nitrate (VmL/VmL) ratio on the AgNP synthesis process under constant reaction conditions (2 mM of AgNO3, 25 °C, light exposure, pH initial without adjustment for 24 h) was determined by mixing the algal extracts (DBio and DSup) and AgNO3 at various ratios of 1:1, 1:2A, 1:4A, 1:9A, 1:2B, 1:4B, and 1:9B. The letter A in the algal extract/AgNO3 ratio indicates that the volume of AgNO3 was changed against that of the of algal extract, which was kept constant, whereas the letter B indicated that the algal extract volume was changed and that of AgNO3 was kept constant. Next, the algal extracts were mixed with 2 mM AgNO3 at optimum ratios and the mixtures were incubated at 40, 60, 80, and 100 °C in a water bath for 1 h while the other reaction conditions were kept constant. After 1 h, all the mixtures were incubated under illumination for 24 h. The effect of the reaction time was determined by exposing the algal extract/precursor mixture to the optimum temperature for 15, 30, and 60 min under constant reaction conditions. The experiment was performed once in the dark and once in the light under optimal conditions after mixing the algal extracts with AgNO3. The effect of the pH was studied by modifying the initial pH of the algal extract/AgNO3 mixture using 1 M HCL or NaOH to 6, 7, 8, and 12 under optimum synthesis reaction conditions. Finally, DBio@AgNPs and DSup@AgNPs were synthesized on a larger scale using the following optimum parameters: DBio@AgNPs: mixing 1 mL algal extract with 9 mL of 2 mM AgNO3 at 25 °C under illumination and pH 7 for 24 h; DSup@AgNPs: mixing 1 mL algal extract with 2 mL of 2 mM AgNO3 at 60 °C for 1 h and under illumination and pH 9.5 for 24 h [19].
To determine the size and shape of the synthesized DBio@AgNPs and DSup@AgNPs, the samples were examined using transmission and scanning electron microscopy. In brief, 1 mL of the AgNP suspension was centrifuged at 13,000× g rpm for 15 min and washed at least thrice with distilled H2O. The samples were suspended in 1 mL water and sonicated for 15 min in a water bath. Then, AgNP suspension drops (10 µL/drop) were placed on carbon-coated copper grids (300 mesh) and air-died in a laminar flow. The samples were examined using TEM (JEM-1400Flash, Jeol, Akishima, Japan) at 120 kV. Similarly, 10 µL of AgNP suspensions was dropped onto a glass piece embedded in a copper stub and coated with platinum using a coater. The samples were examined using SEM (JEC-3000FC, Jeol, Japan) at 15 kV. To determine the elemental composition and distribution of DBio@AgNPs and DSup@AgNPs, the samples were dried using a lyophilizer, and a small quantity of each AgNP powder was transferred to a carbon strip attached to the SEM stub for examination using an EDx detector conjugated to the SEM. The hydrodynamic diameters and potential charges of the DBio@AgNP and DSup@AgNP aqueous suspensions were determined using a Zetasizer (Malvern, UK). FTIR spectroscopy (Shimadzu, Kyoto, Japan) was performed in the range of 400–4000 cm−1 to study the surface chemistry of DBio@AgNPs and DSup@AgNPs (in powder form) and elucidate the interaction between the algal biomolecules and Ag ions. Notably, the functional groups of the biomolecules present in the algal biomass extract and cell-free medium were detected [19].
3.3.2. Anticancer Activity of DBio@AgNPs and DSup@AgNPs
The antiproliferative and biocompatibility effects of 500 µg/mL of DBio@AgNPs and DSup@AgNPs were evaluated against human breast cancer cells (MCF-7) and normal kidney cells of African green monkey (Vero) that were grown on complete DMEM medium (10% fetal bovine serum and 50 U/mL of penicillin and streptomycin) in an incubator at 37 °C and 5% CO2. After 75% confluency was reached, the cells were passaged using trypsin–EDTA, counted, seeded (5 × 103 cells/well) into 96-well plates, and incubated for 24 h under the same conditions. For the DBio@AgNPs and DSup@AgNPs suspension preparation: 1 mg of DBio@AgNPs and DSup@AgNPs were mixed with 1 mL of DMEM and sonicated for 15 min until well dispersed in the medium. The samples were filtrated using 0.45 µm sterilized syringe filter. Then, 2-fold serial dilution samples (500, 250, 125, 62.5, 31.25, 15.6, 7.8, and 3.9 µg/mL) were prepared and applied to the cells, followed by incubation for 24 h. Then, the old media were replaced with fresh media, and 10 µL of MTT solution (5 mg/mL) was added to the cells, which were kept for 4 h in an incubator. Then, the media were discarded and 100 µL/well of DMSO was added. The plates were kept for 15 min. The optical absorbance of the sample was measured at 570 nm, and the cell viability % was estimated using the following equation [19,60]:
(Abs(treated)/(Abs(control)) × 100
3.3.3. Antibacterial Activity of DBio@AgNPs and DSup@AgNPs
The inhibitory effect of 1000 µg/mL of DBio@AgNPs and DSup@AgNPs was detected against Staphylococcus aureus ATCC 29213, Bacillus subtilis ATCC6633, and Shigella flexneri (clinical isolate) using the agar well diffusion method. The bacterial strains were grown in nutrient broth for up to 18 h at 37 °C and maintained by continuous subculturing in broth and agar media. Nutrient agar plates of bacterial suspension (2.5–3.6 × 106 CFU/mL) were prepared in 8 mm diameter wells. The bacteria were treated with 100 μL of 1000 µg/mL of DBio@AgNPs and DSup@AgNPs suspensions (sonicated for 15 min before treatment) and kept in the incubator at 37 °C for 24 h. Notably, ciprofloxacin (5 µg/mL) was used as a positive control. The diameters of the inhibition zones (in mm) were measured using a transparent ruler.
The minimum inhibitory concentrations (MIC) of 500 µg/mL DBio@AgNPs and DSup@AgNPs were determined using the resazurin dye method described by Elshikh et al. [61]. Serial dilution concentrations of DBio@AgNPs and DSup@AgNPs (500, 250, 125, 62.5, 31.25, 15.62, 7.8, 3.9, 1.95, and 0.98 µg/mL) were prepared and 100 µL of NP suspension was mixed with 100 µL of bacterial suspension (2.5–3.6 × 106 CFU/mL) in 96-well plates. Two control groups were established: a positive control group containing an untreated bacterial suspension and a negative control group consisting of medium only to assess sterility. The plates were left to culture overnight at a temperature of 37 °C. Following incubation, the bacteria were incubated with 30 µL of a 0.015% resazurin dye solution at a temperature of 37 °C for 4 h. The absorbance of the samples was quantified at 570 nm using a plate reader (Hercules, CA, USA). After 4 h, the column was considered above the MIC value if there was no color change (the color of the resazurin indicator, blue, remained unchanged).
3.4. Statistical Analysis
GraphPad Prism v.9.3.1 (GraphPad Software Inc., San Diego, CA, USA), Origin 8 (OriginLab Corporation, Northampton, MA, USA), and ImageJ 1.52a (National Institutes of Health, Bethesda, MD, USA) software were used to analyze the data in the current study. The data were presented as the mean ± standard error of the mean (SEM). Significance was detected using a one-way analysis of variance (ANOVA). The data were considered statistically significant at a p value < 0.05.
4. Conclusions
To the best of our knowledge, the current study is the first to represent the potential of the novel D. edaphica strain CCAP 6006/5 to biosynthesize AgNPs using its biomass extract and cell-free medium and to report the phytochemical compositions of these microalgae using GC-MS. Moreover, this study focused on determining the optimum reaction parameters to synthesize small, stable, and well-dispersed AgNPs by controlling parameters such as the AgNO3 concentration, algal/silver nitrate ratio, temperature, reaction time, illumination, and pH. The results showed that D. edaphica biomass extract and cell-free medium have great bioreduction potential to form small-sized DBio@AgNPs and DSup@AgNPs. Several physicochemical parameters, such as the AgNO3 concentration, algal/silver nitrate ratio, temperature, reaction time, illumination, and pH, influence the size and stability of these NPs. This indicates that during the biological synthesis of NPs using microalgae, the reaction must be optimized to regulate their physicochemical characteristics. DBio@AgNPs and DSup@AgNPs present quasi-spherical shapes, with small sizes of 15.0 ± 1.0 nm and 12.0 ± 0.8 nm, respectively. The HDs of DBio@AgNPs and DSup@AgNPs were 77.9 and 62.7 nm and the charges were −24.4 and −25.8 mV, respectively. This negativity on the NP surface could be attributed to the algal corona surrounding the AgNPs. The surface of these biogenic AgNPs are coated with various functional groups, including O–H, C–H, C=C/N–H, C–O, C=O, and C–Br, suggesting that algal polysaccharides and proteins operate as reductants, whereas polysaccharides and fatty acids act as stabilizers during NP formation. The GC-MS analysis revealed that elaidic acid (18.36%) and monoolein (17.37%) were the most abundant biomolecules in the algal extracts, indicating that these fatty acids may affect AgNP stabilization. DSup@AgNPs showed more potent anticancer activity against MCF-7 cells and better biocompatibility with Vero cells than DBio@AgNPs. In contrast, DBio@AgNPs and DSup@AgNPs showed greater biocidal activity against Gram-negative and Gram-positive bacteria than Chem@AgNPs and AgNO3. These results indicate that D. edaphica strain CCAP 6006/5 is a facile and eco-friendly biomachine for the synthesis of AgNPs and may be used as a powerful therapeutic agent against cancer and infectious diseases.
Author Contributions
Conceptualization, R.S.H., M.A.A. (Mohamed Abdelaal Ali) and M.M.B.-M.; methodology, R.S.H., M.A.A. (Mohamed Abdelaal Ali) and M.M.B.-M.; software, R.S.H.; validation R.S.H., M.A.A. (Mohamed Abdelaal Ali) and M.M.B.-M.; formal analysis, R.S.H.; investigation, R.S.H., M.A.A. (Mohamed Abdelaal Ali) and M.M.B.-M.; resources, M.A.A. (Mohamed Abdelaal Ali), M.A.M. and M.M.B.-M.; data curation, R.S.H. and M.A.A. (Mohamed Abdelaal Ali); writing—original draft preparation, R.S.H.; writing—review and editing, R.S.H.; visualization, R.S.H. and M.A.A. (Mohamed Abdelaal Ali); supervision, M.M.B.-M.; project administration, M.M.B.-M., H.E.A., M.A.M. and M.A.A. (Mariam Abdulaziz Alkhateeb); funding acquisition, H.E.A., M.A.A. (Mariam Abdulaziz Alkhateeb) and M.A.M. All authors have read and agreed to the published version of the manuscript.
Funding
This work was funded by the Deanship of Scientific Research at Princess Nourah bint Abdulrahman University through the Research Groups Program (grant no. RGP-1441-0030).
Institutional Review Board Statement
Not applicable.
Informed Consent Statement
Not applicable.
Data Availability Statement
Additional data to those presented here are available from the corresponding author upon reasonable request.
Conflicts of Interest
The authors declare no conflicts of interest.
References
- Ravindran, A.; Chandran, P.; Khan, S.S. Biofunctionalized silver nanoparticles: Advances and prospects. Colloids Surf. B Biointerfaces 2013, 105, 342–352. [Google Scholar] [CrossRef]
- Zheng, K.; Setyawati, M.I.; Leong, D.T.; Xie, J. Antimicrobial silver nanomaterials. Coord. Chem. Rev. 2018, 357, 1–17. [Google Scholar] [CrossRef]
- Qi, M.; Wang, X.; Chen, J.; Liu, Y.; Liu, Y.; Jia, J.; Li, L.; Yue, T.; Gao, L.; Yan, B. Transformation, Absorption and Toxicological Mechanisms of Silver Nanoparticles in the Gastrointestinal Tract Following Oral Exposure. ACS Nano 2023, 17, 8851–8865. [Google Scholar] [CrossRef]
- De Moura, M.R.; Mattoso, L.H.; Zucolotto, V. Development of cellulose-based bactericidal nanocomposites containing silver nanoparticles and their use as active food packaging. J. Food Eng. 2012, 109, 520–524. [Google Scholar] [CrossRef]
- Jadhav, K.; Deore, S.; Dhamecha, D.; Hr, R.; Jagwani, S.; Jalalpure, S.; Bohara, R. Phytosynthesis of silver nanoparticles: Characterization, biocompatibility studies, and anticancer activity. ACS Biomater. Sci. Eng. 2018, 4, 892–899. [Google Scholar] [CrossRef]
- Wang, Y.; Wei, S. Green fabrication of bioactive silver nanoparticles using Mentha pulegium extract under alkaline: An enhanced anticancer activity. ACS Omega 2021, 7, 1494–1504. [Google Scholar] [CrossRef]
- Pucelik, B.; Sułek, A.; Borkowski, M.; Barzowska, A.; Kobielusz, M.; Dąbrowski, J.M. Synthesis and characterization of size-and charge-tunable silver nanoparticles for selective anticancer and antibacterial treatment. ACS Appl. Mater. Interfaces 2022, 14, 14981–14996. [Google Scholar] [CrossRef]
- Panáček, A.; Kolář, M.; Večeřová, R.; Prucek, R.; Soukupová, J.; Kryštof, V.; Hamal, P.; Zbořil, R.; Kvítek, L. Antifungal activity of silver nanoparticles against Candida spp. Biomaterials 2009, 30, 6333–6340. [Google Scholar] [CrossRef]
- Jeevanandam, J.; Krishnan, S.; Hii, Y.S.; Pan, S.; Chan, Y.S.; Acquah, C.; Danquah, M.K.; Rodrigues, J. Synthesis approach-dependent antiviral properties of silver nanoparticles and nanocomposites. J. Nanostruct. Chem. 2022, 12, 809–831. [Google Scholar] [CrossRef]
- Gaillet, S.; Rouanet, J.-M. Silver nanoparticles: Their potential toxic effects after oral exposure and underlying mechanisms—A review. Food Chem. Toxicol. 2015, 77, 58–63. [Google Scholar] [CrossRef]
- Shreyash, N.; Bajpai, S.; Khan, M.A.; Vijay, Y.; Tiwary, S.K.; Sonker, M. Green synthesis of nanoparticles and their biomedical applications: A review. ACS Appl. Nano Mater. 2021, 4, 11428–11457. [Google Scholar] [CrossRef]
- Hamida, R.S.; Ali, M.A.; Redhwan, A.; Bin-Meferij, M.M. Cyanobacteria—A promising platform in green nanotechnology: A review on nanoparticles fabrication and their prospective applications. Int. J. Nanomed. 2020, 15, 6033–6066. [Google Scholar] [CrossRef]
- Asmathunisha, N.; Kathiresan, K. A review on biosynthesis of nanoparticles by marine organisms. Colloids Surf. B Biointerfaces 2013, 103, 283–287. [Google Scholar] [CrossRef]
- Gour, A.; Jain, N.K. Advances in green synthesis of nanoparticles. Artif. Cells Nanomed. Biotechnol. 2019, 47, 844–851. [Google Scholar] [CrossRef]
- Wang, Y.; Wei, S.; Wang, K.; Wang, Z.; Duan, J.; Cui, L.; Zheng, H.; Wang, Y.; Wang, S. Evaluation of biosynthesis parameters, stability and biological activities of silver nanoparticles synthesized by Cornus Officinalis extract under 365 nm UV radiation. RSC Adv. 2020, 10, 27173–27182. [Google Scholar] [CrossRef]
- Aziz, N.; Faraz, M.; Pandey, R.; Shakir, M.; Fatma, T.; Varma, A.; Barman, I.; Prasad, R. Facile algae-derived route to biogenic silver nanoparticles: Synthesis, antibacterial, and photocatalytic properties. Langmuir 2015, 31, 11605–11612. [Google Scholar] [CrossRef]
- Bulgariu, L.; Bulgariu, D. Bioremediation of toxic heavy metals using marine algae biomass. Green Mater. Wastewater Treat. 2020, 542, 69–98. [Google Scholar]
- Sijil, P.; Cherita, C.; Jethani, H.; Chauhan, V.S. Chapter 1. Microalgae as a Renewable and Sustainable Source of High Value Metabolites; The Royal Society of Chemistry: London, UK, 2022; pp. 1–26. [Google Scholar]
- Hamida, R.S.; Ali, M.A.; Mugren, N.; Al-Zaban, M.I.; Bin-Meferij, M.M.; Redhwan, A. Planophila laetevirens-Mediated Synthesis of Silver Nanoparticles: Optimization, Characterization, and Anticancer and Antibacterial Potentials. ACS Omega 2023, 8, 29169–29188. [Google Scholar] [CrossRef]
- Gahlawat, G.; Choudhury, A.R. A review on the biosynthesis of metal and metal salt nanoparticles by microbes. RSC Adv. 2019, 9, 12944–12967. [Google Scholar] [CrossRef]
- Wen, J.; Gao, F.; Liu, H.; Wang, J.; Xiong, T.; Yi, H.; Zhou, Y.; Yu, Q.; Zhao, S.; Tang, X. Metallic nanoparticles synthesized by algae: Synthetic route, action mechanism, and the environmental catalytic applications. J. Environ. Chem. Eng. 2023, 12, 111742. [Google Scholar] [CrossRef]
- Darienko, T.; Rad-Menéndez, C.; Campbell, C.N.; Pröschold, T. Molecular phylogeny of unicellular marine coccoid green algae revealed new insights into the systematics of the Ulvophyceae (Chlorophyta). Microorganisms 2021, 9, 1586. [Google Scholar] [CrossRef]
- Kulkarni, C.V.; Wachter, W.; Iglesias-Salto, G.; Engelskirchen, S.; Ahualli, S. Monoolein: A magic lipid? Phys. Chem. Chem. Phys. 2011, 13, 3004–3021. [Google Scholar] [CrossRef]
- Sobczak-Kupiec, A.; Malina, D.; Wzorek, Z.; Zimowska, M. Influence of silver nitrate concentration on the properties of silver nanoparticles. Micro Nano Lett. 2011, 6, 656–660. [Google Scholar] [CrossRef]
- Haji, B.S.; Barzinjy, A.A. Citrullus Colocynthis Fruit Extract Mediated Green Synthesis of Silver Nanoparticles: The Impact of pH, Temperature, and Silver Nitrate Concentration. e-J. Surf. Sci. Nanotechnol. 2022, 21, 61–71. [Google Scholar] [CrossRef]
- Piñero, S.; Camero, S.; Blanco, S. Silver nanoparticles: Influence of the temperature synthesis on the particles’ morphology. J. Phys. Conf. Ser. 2017, 786, 012020. [Google Scholar] [CrossRef]
- Dong, C.; Zhang, X.; Cai, H.; Cao, C. Facile and one-step synthesis of monodisperse silver nanoparticles using gum acacia in aqueous solution. J. Mol. Liq. 2014, 196, 135–141. [Google Scholar] [CrossRef]
- Hamida, R.S.; Ali, M.A.; Sharif, F.T.; Sonbol, H.; Bin-Meferij, M.M. Biofabrication of silver nanoparticles using Nostoc muscorum Lukesova 2/91: Optimization, characterization, and biological applications. Int. J. Nanomed. 2023, 18, 5625–5649. [Google Scholar] [CrossRef]
- Lengke, M.F.; Fleet, M.E.; Southam, G. Biosynthesis of silver nanoparticles by filamentous cyanobacteria from a silver (I) nitrate complex. Langmuir 2007, 23, 2694–2699. [Google Scholar] [CrossRef]
- Prasad, T.N.; Kambala, V.S.R.; Naidu, R. Phyconanotechnology: Synthesis of silver nanoparticles using brown marine algae Cystophora moniliformis and their characterisation. J. Appl. Phycol. 2013, 25, 177–182. [Google Scholar] [CrossRef]
- Liu, H.; Zhang, H.; Wang, J.; Wei, J. Effect of temperature on the size of biosynthesized silver nanoparticle: Deep insight into microscopic kinetics analysis. Arab. J. Chem. 2020, 13, 1011–1019. [Google Scholar] [CrossRef]
- Mohandass, C.; Vijayaraj, A.; Rajasabapathy, R.; Satheeshbabu, S.; Rao, S.; Shiva, C.; De-Mello, I. Biosynthesis of silver nanoparticles from marine seaweed Sargassum cinereum and their antibacterial activity. Indian J. Pharm. Sci. 2013, 75, 606. [Google Scholar]
- Hamal, D.B.; Klabunde, K.J. Synthesis, characterization, and visible light activity of new nanoparticle photocatalysts based on silver, carbon, and sulfur-doped TiO2. J. Colloid Interface Sci. 2007, 311, 514–522. [Google Scholar] [CrossRef]
- Patel, V.; Berthold, D.; Puranik, P.; Gantar, M. Screening of cyanobacteria and microalgae for their ability to synthesize silver nanoparticles with antibacterial activity. Biotechnol. Rep. 2015, 5, 112–119. [Google Scholar] [CrossRef]
- Gontijo, L.A.P.; Raphael, E.; Ferrari, D.P.S.; Ferrari, J.L.; Lyon, J.P.; Schiavon, M.A. pH effect on the synthesis of different size silver nanoparticles evaluated by DLS and their size-dependent antimicrobial activity. Matéria 2020, 25, e-12845. [Google Scholar] [CrossRef]
- Pernas-Pleite, C.; Conejo-Martínez, A.M.; Fernández Freire, P.; Hazen, M.J.; Marín, I.; Abad, J.P. Microalga Broths Synthesize Antibacterial and Non-Cytotoxic Silver Nanoparticles Showing Synergy with Antibiotics and Bacterial ROS Induction and Can Be Reused for Successive AgNP Batches. Int. J. Mol. Sci. 2023, 24, 16183. [Google Scholar] [CrossRef]
- Jena, J.; Pradhan, N.; Dash, B.P.; Sukla, L.B.; Panda, P.K. Biosynthesis and characterization of silver nanoparticles using microalga Chlorococcum humicola and its antibacterial activity. Int. J. Nanomater. Biostruct. 2013, 3, 1–8. [Google Scholar]
- Kusumaningrum, H.P.; Zainuri, M.; Marhaendrajaya, I.; Subagio, A. Nanosilver microalgae biosynthesis: Cell appearance based on SEM and EDX methods. J. Phys. Conf. Ser. 2018, 1025, 012084. [Google Scholar] [CrossRef]
- Chokshi, K.; Pancha, I.; Ghosh, T.; Paliwal, C.; Maurya, R.; Ghosh, A.; Mishra, S. Green synthesis, characterization and antioxidant potential of silver nanoparticles biosynthesized from de-oiled biomass of thermotolerant oleaginous microalgae Acutodesmus dimorphus. RSC Adv. 2016, 6, 72269–72274. [Google Scholar] [CrossRef]
- Cekuolyte, K.; Gudiukaite, R.; Klimkevicius, V.; Mazrimaite, V.; Maneikis, A.; Lastauskiene, E. Biosynthesis of Silver Nanoparticles Produced Using Geobacillus spp. Bacteria. Nanomaterials 2023, 13, 702. [Google Scholar] [CrossRef]
- Abdullah, B.M.; Salih, N.; Salimon, J. Optimization of the chemoenzymatic mono-epoxidation of linoleic acid using D-optimal design. J. Saudi Chem. Soc. 2014, 18, 276–287. [Google Scholar] [CrossRef]
- Lu, Y.; Lu, X.; Mayers, B.T.; Herricks, T.; Xia, Y. Synthesis and characterization of magnetic Co nanoparticles: A comparison study of three different capping surfactants. J. Solid State Chem. 2008, 181, 1530–1538. [Google Scholar] [CrossRef]
- Mora-Godínez, S.; Contreras-Torres, F.F.; Pacheco, A. Characterization of Silver Nanoparticle Systems from Microalgae Acclimated to Different CO2 Atmospheres. ACS Omega 2023, 8, 21969–21982. [Google Scholar] [CrossRef] [PubMed]
- Yin, N.; Liu, Q.; Liu, J.; He, B.; Cui, L.; Li, Z.; Yun, Z.; Qu, G.; Liu, S.; Zhou, Q. Silver nanoparticle exposure attenuates the viability of rat cerebellum granule cells through apoptosis coupled to oxidative stress. Small 2013, 9, 1831–1841. [Google Scholar] [CrossRef] [PubMed]
- Moore, T.L.; Rodriguez-Lorenzo, L.; Hirsch, V.; Balog, S.; Urban, D.; Jud, C.; Rothen-Rutishauser, B.; Lattuada, M.; Petri-Fink, A. Nanoparticle colloidal stability in cell culture media and impact on cellular interactions. Chem. Soc. Rev. 2015, 44, 6287–6305. [Google Scholar] [CrossRef] [PubMed]
- Park, M.V.; Neigh, A.M.; Vermeulen, J.P.; de la Fonteyne, L.J.; Verharen, H.W.; Briedé, J.J.; van Loveren, H.; de Jong, W.H. The effect of particle size on the cytotoxicity, inflammation, developmental toxicity and genotoxicity of silver nanoparticles. Biomaterials 2011, 32, 9810–9817. [Google Scholar] [CrossRef] [PubMed]
- Philpott, D.J.; Edgeworth, J.D.; Sansonetti, P.J. The pathogenesis of Shigella flexneri infection: Lessons from in vitro and in vivo studies. Philos. Trans. R. Soc. Lond. Ser. B Biol. Sci. 2000, 355, 575–586. [Google Scholar] [CrossRef]
- Cheung, G.Y.; Bae, J.S.; Otto, M. Pathogenicity and virulence of Staphylococcus aureus. Virulence 2021, 12, 547–569. [Google Scholar] [CrossRef] [PubMed]
- Errington, J.; Aart, L.T.v.d. Microbe Profile: Bacillus subtilis: Model organism for cellular development, and industrial workhorse. Microbiology 2020, 166, 425–427. [Google Scholar] [CrossRef]
- Meikle, T.G.; Dyett, B.P.; Strachan, J.B.; White, J.; Drummond, C.J.; Conn, C.E. Preparation, characterization, and antimicrobial activity of cubosome encapsulated metal nanocrystals. ACS Appl. Mater. Interfaces 2020, 12, 6944–6954. [Google Scholar] [CrossRef]
- More, P.R.; Pandit, S.; Filippis, A.D.; Franci, G.; Mijakovic, I.; Galdiero, M. Silver nanoparticles: Bactericidal and mechanistic approach against drug resistant pathogens. Microorganisms 2023, 11, 369. [Google Scholar] [CrossRef]
- Li, W.-R.; Xie, X.-B.; Shi, Q.-S.; Duan, S.-S.; Ouyang, Y.-S.; Chen, Y.-B. Antibacterial effect of silver nanoparticles on Staphylococcus aureus. Biometals 2011, 24, 135–141. [Google Scholar] [CrossRef] [PubMed]
- Yang, J.; Lee, J.Y.; Too, H.-P. A general phase transfer protocol for synthesizing alkylamine-stabilized nanoparticles of noble metals. Anal. Chim. Acta 2007, 588, 34–41. [Google Scholar] [CrossRef]
- Salvioni, L.; Galbiati, E.; Collico, V.; Alessio, G.; Avvakumova, S.; Corsi, F.; Tortora, P.; Prosperi, D.; Colombo, M. Negatively charged silver nanoparticles with potent antibacterial activity and reduced toxicity for pharmaceutical preparations. Int. J. Nanomed. 2017, 12, 2517–2530. [Google Scholar] [CrossRef] [PubMed]
- Tripathi, D.K.; Tripathi, A.; Shweta; Singh, S.; Singh, Y.; Vishwakarma, K.; Yadav, G.; Sharma, S.; Singh, V.K.; Mishra, R.K. Uptake, accumulation and toxicity of silver nanoparticle in autotrophic plants, and heterotrophic microbes: A concentric review. Front. Microbiol. 2017, 8, 07. [Google Scholar] [CrossRef] [PubMed]
- Kong, I.C.; Ko, K.-S.; Koh, D.-C. Evaluation of the effects of particle sizes of silver nanoparticles on various biological systems. Int. J. Mol. Sci. 2020, 21, 8465. [Google Scholar] [CrossRef] [PubMed]
- Bolch, C.J.; Orr, P.T.; Jones, G.J.; Blackburn, S.I. Genetic, morphological, and toxicological variation among globally distributed strains of Nodularia (Cyanobacteria). J. Phycol. 1999, 35, 339–355. [Google Scholar] [CrossRef]
- Hamida, R.S.; Ali, M.A.; Almohawes, Z.N.; Alahdal, H.; Momenah, M.A.; Bin-Meferij, M.M. Green synthesis of hexagonal silver nanoparticles using a novel microalgae coelastrella aeroterrestrica strain BA_Chlo4 and resulting anticancer, antibacterial, and antioxidant activities. Pharmaceutics 2022, 14, 2002. [Google Scholar] [CrossRef] [PubMed]
- Khaw, Y.S.; Khong, N.M.H.; Shaharuddin, N.A.; Yusoff, F.M. A simple 18S rDNA approach for the identification of cultured eukaryotic microalgae with an emphasis on primers. J. Microbiol. Methods 2020, 172, 105890. [Google Scholar] [CrossRef] [PubMed]
- Mosmann, T. Rapid colorimetric assay for cellular growth and survival: Application to proliferation and cytotoxicity assays. J. Immunol. Methods 1983, 65, 55–63. [Google Scholar] [CrossRef]
- Elshikh, M.; Ahmed, S.; Funston, S.; Dunlop, P.; McGaw, M.; Marchant, R.; Banat, I.M. Resazurin-based 96-well plate microdilution method for the determination of minimum inhibitory concentration of biosurfactants. Biotechnol. Lett. 2016, 38, 1015–1019. [Google Scholar] [CrossRef]
Disclaimer/Publisher’s Note: The statements, opinions and data contained in all publications are solely those of the individual author(s) and contributor(s) and not of MDPI and/or the editor(s). MDPI and/or the editor(s) disclaim responsibility for any injury to people or property resulting from any ideas, methods, instructions or products referred to in the content. |
© 2024 by the authors. Licensee MDPI, Basel, Switzerland. This article is an open access article distributed under the terms and conditions of the Creative Commons Attribution (CC BY) license (https://creativecommons.org/licenses/by/4.0/).